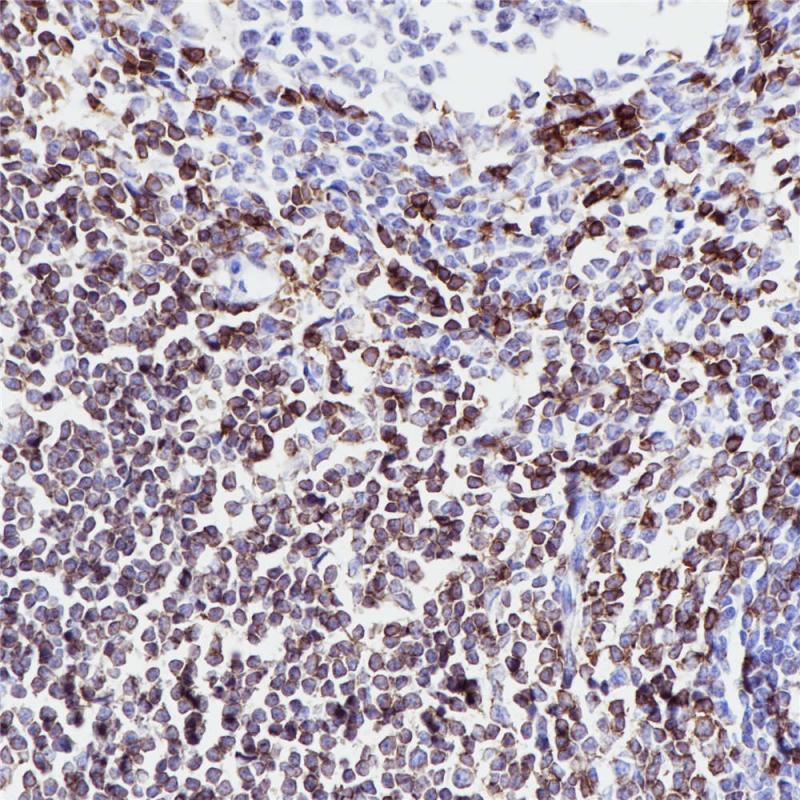
扁桃体 CD5 (BP6090) 染色

产品中心
扁桃体 CD5 (BP6090) 染色

脾 CD5 (BP6090) 染色
CD5 重组兔单克隆抗体
CD5抗原分布于分布于大多数T 细胞及胸腺细胞(95%)及多数T细胞淋巴瘤。套细胞淋巴瘤和慢性B淋巴细胞白血病和小淋巴细胞淋巴瘤也可阳性,而滤泡性淋巴瘤、毛细胞白血病、大细胞淋巴瘤等为阴性。此抗体有助于对B细胞淋巴瘤进行分类,并且可能有助于区分胸腺癌和肺癌。
Specifications
- 目录号
- BX50085
- 克隆号
- BP6090
- 阳性对照
- 阑尾
- 亚细胞定位
- 细胞膜
- 组织类型
- FFPE
- 修复方式
- HIER
- 稀释比
- 1:100-1:200
- 规格
- 100μl/vial, 1ml/vial
- 用途
- RUO
Reference
1.Gloria Soldevila, et al. J Leukoc Biol. 2019;1-14.
2.Manjun Zhao, Ningning Duan,et al. Autoimmunity.2019;1-9.


